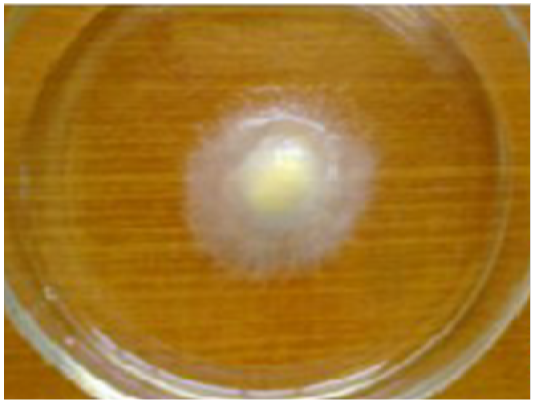

Journal of Infection and Molecular Biology
Review Article
J. Inf. Mol. Biol. 6(2): 36-44
Figure 1
The life cycle of Saprolegnia parasitica. The life cycle consists of both sexual and asexual stages. The figure is not drawn to scale, have been copied from, Andrew J. Phillips.
Figure 2
Showing white cotton wool like tuft on dorsal portion of fungal infected gold fish.
Figure 3
Showing culture of fungus on potato dextrose agar isolated from fungal infected fish.
Figure 4
Showing culture of aquatic fungi on soyabean sead.